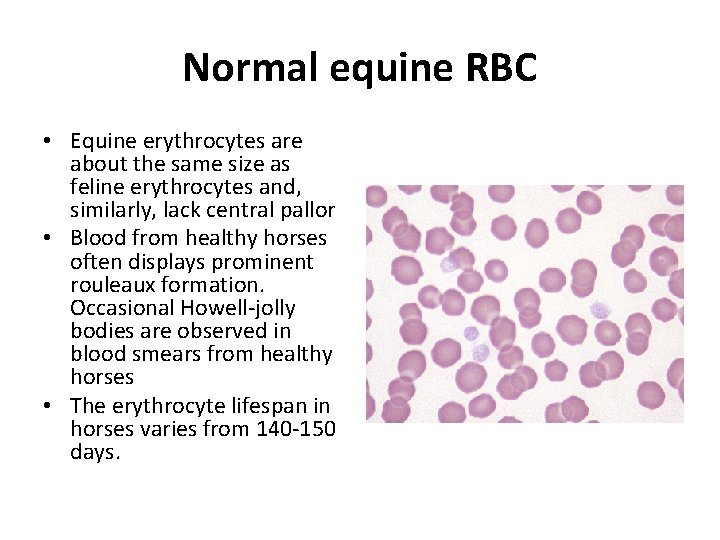
Normal equine RBC • Equine erythrocytes are about the same size as feline erythrocytes

Equine Pathology Normal equine RBC Equine erythrocytes are

Equine Pathology
Normal equine RBC • Equine erythrocytes are about the same size as feline erythrocytes and, similarly, lack central pallor • Blood from healthy horses often displays prominent rouleaux formation. Occasional Howell-jolly bodies are observed in blood smears from healthy horses • The erythrocyte lifespan in horses varies from 140 -150 days.

Clinical Chemistry Normal Values for Horses ALB 2. 5 - 4. 2 g/d. L ALKP 109 - 315 U/L ALT 3 - 25 U/L AMYL < 30 U/L AST 205 - 555 U/L BUN 8 -27 mg/d. L Ca 10. 7 - 13. 4 mg/d. L Ionized Ca 50 - 60 % of total Ca CHOL 51 - 109 mg/d. L Ck 90 565 U / L Cl 94 - 102 mmol/L CO 2 24 - 31 mmol/L CREA 0. 6 -1. 8 mg/d. L GGT 12 - 45 U/L GLU 72 -114 mg/d. L K 2. 7 - 4. 9 mmol/L LDH 520 - 1480 U/L LIPA 460 - 870 U/L Mg 1. 6 - 2. 5 mg/d. L Na 132 -141 mmol/L PHOS 1. 9 - 5. 4 mg/d. L TBIL 0. 1 - 1. 9 mg/d. L TP 4. 6 - 6. 9 g/d. L TRIG 11 - 59 mg/d. L URIC < 0. 5 mg/d. L

Hematology Normal Values for Horses WBC 5, 500 - 12, 500 /cubic mm Platelets 100, 000 -600, 000 /cubic mm Segmented Neutrophil 2700 6700/cubic mm or 30 - 65% RBC 6, 500, 000 -12, 500, 000 /cubic mm Bands 0 -100 /cubic mm or 02% MCV 34 -58 fl Lymphocyte 1500 -5500 / cubic mm or 25 -70% Hemoglobin 11 -19 g/d. L Monocyte 0 - 800 /cubic mm or 0. 5 -7% PCV 32 - 52 % Eosinophil 0 - 925 / cubic mm or 0 -11% ACL Fibrinogen 150 - 375 mg/ d. L Basophil 0 -170 / cubic mm or 0 -3% Fibrinogen (Miller) 200 - 450 mg/d. L
- Slides: 4